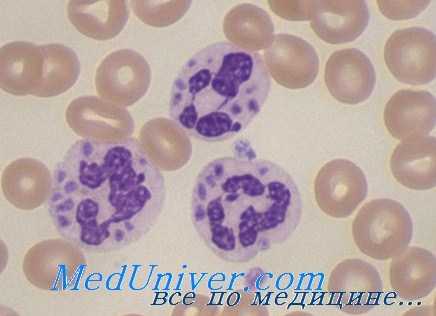
хроническая гранулематозная болезнь

Клиника хронической гранулематозной болезни. Морфология гранулематозной болезни
Добавил пользователь Владимир З. Обновлено: 19.12.2025
Иммунодефицит с экземой - синдром Вискотта — Олдрича. Хроническая гранулематозная болезнь
Иммунодефицит с экземой и тромбоцитопенией (Вискотта — Олдрича синдром) представляет собой синдром, характеризующийся неспособностью к образованию антител против антигенов, содержащих полисахариды, тромбоцитопенией, экземой и повторными инфекциями. Синдром впервые описан в 1937 г. Wiskott, Aldrich — в. 1954 г. Этиология —рецессивная сцепленная с Х-хромосомой наследственность. Патогенез неясен.
Установлено, что имеет место неспособность к распознаванию полисахаридных антигенов, в связи с чем предполагают, что нормально сформированная лимфоидная ткань повреждается вторично из-за повторных инфекционных заболеваний и иммунный дефицит с возрастом нарастает. Характерны сыпь, появляющаяся в возрасте нескольких месяцев и повторные инфекционные заболевания (вирусные и бактериальные), чаще отит и пневмония.
Инфекционные заболевания сопровождаются усилением тромбоцитопении и кровоизлияниями. В более старшем возрасте может наблюдаться повторное инфицирование herpes simplex, принимающее иногда тяжелый характер с летальным исходом. Из инфекций встречается цитомегалия и пневмоцистная пневмония, часто наблюдается аллергия к пищевым и другим аллергенам. В результате кровоточивости развивается анемия. Наблюдается нарастающее с возрастом снижение IgM и повышение IgA и Е.
Уровень комплемента, интерферона, функция лейкоцитов нормальные. Указывают на нарушения клеточного иммунитета, что установлено на изолированных лимфоцитах крови. Отмечается лимфопения. Степень тромбоцитопеиии варьирует. Прогноз неблагоприятный, средний возраст больных 3,5 года.
Изменения в лимфатических узлах зависят от возраста больного. У маленьких детей имеется лишь слабая степень истощения Т-зависимой зоны на фоне нормальной структуры фолликулов. У детей школьного возраста — отчетливая картина истощения Т- и В-зон, фолликулы отсутствуют, подобные изменения наблюдаются в селезенке и желудочно-кишечном тракте. Однако, по другим данным, фолликулы в кишечнике нормальные. В тимусе описывается гипоплазия, нормальная структура при уменьшении массы органа и атрофия его.
В костном мозге — нормальное или уменьшенное количество мегакариоцитов. В легких — хроническая пневмония. Выражен геморрагический диатез. Описываются множественные субпериостальные гематомы, кровоизлияния в желудочно-кишечный тракт и другие органы. Экзема располагается в области локтевых, паховых, подколенных складок.

Хроническая гранулематозная болезнь
Хроническая гранулематозная болезнь (ХГБ) представляет собой наследственный дефект бактерицидной функции лейкоцитов с повторными гранулематозными инфекционными поражениями кожи, легких, лимфатических узлов и печени, с гипергаммаглобулинемией, анемией и лейкоцитозом. Впервые заболевание описали Berends и соавт. в 1957 г.
В связи с тем что дети погибали в раннем детском, возрасте от повторных бактериальных инфекций, оно названо фатальной гранулематозной болезнью детей. Заболевание носит характер наследственного рецессивного страдания, генотипичсски сцепленного с Х-хромосомой. Болеют мальчики. Носителем патологического гена являются женщины, которые сами не болеют, однако у них имеет место снижение бактерицидной способности лейкоцитов по сравнению со здоровыми субъектами.
Патогенез связан с резко сниженной активностью ферментов гексозомонофосфатного шунта, что приводит к уменьшению продукции перекиси водорода, от которой в свою очередь зависит бактерицидный эффект лейкоцитов. Фагоцитоз осуществляется, но бактерицидный эффект отсутствует. Киллерный эффект нарушен также по отношению к дрожжеподобным грибам рода кандида.
Интересна сохранность бактерицидного эффекта по отношению к стрептококку и пневмококку, что зависит от способности самих этих микробов продуцировать перекись водорода, поэтому у больных с ХГБ не наблюдается инфекционных заболеваний, вызванных стрептококком и пневмококком. В качестве возбудителей преобладают золотистый стафилококк, кишечная палочка, протей, сальмонеллы, грибы рода кандида. Удалось показать, что, помимо нарушения бактерицидной функции нейтрофилов, она снижена у эозинофилов и моноцитов, поэтому при ХГБ повреждена вся фагоцитарная система организма.
Наличие при хронической гранулематозной болезни в области гранулем скоплений липохромов и мукополисахаридов в фагоцитах свидетельствует об обменных нарушениях. Однако их природа остается невыясненной — либо эти нарушения возникают вторично под влиянием инфекционных процессов, либо они являются результатом первичного обменного дефекта фагоцитарной системы.
Информация на сайте подлежит консультации лечащим врачом и не заменяет очной консультации с ним.
См. подробнее в пользовательском соглашении.
Клиника хронической гранулематозной болезни. Морфология гранулематозной болезни
Клиническими признаками являются кожные поражения, возникающие в первые месяцы жизни в виде экзематозных изменений с нагноением в области ушных раковин и вокруг носа, сопровождающиеся регионарным лимфаденитом. В дальнейшем вовлекаются легкие, печень, селезенка, кости, где формируются абсцессы.
Процесс в легких обнаруживается чаще всего и осложняется эмпиемой. Лечение антибиотиками не дает эффекта и заболевание приобретает затяжной, персистирующий характер. Остеомиелит наблюдается чаще в области мелких костей рук и стоп.
При длительном лечении антибиотиками процесс в костях может купироваться. Наблюдается лейкоцитоз, анемия, ускорение СОЭ и гипергаммаглобулинемия с увеличением количества всех трех видов Ig. Характерным для ХГБ является негативный тест с нитроголубым тетразолием.
Смысл теста заключается в том, что окисление нитроголубого сопровождается редукцией краски с выпадением се в виде голубого формазана в цитоплазме лейкоцитов. В норме 80—90% лейкоцитов редуцируют нитроголубой тетразолий при фагоцитозе, что является показателем их бактерицидной (окислительной) активности.

У больных хронической гранулематозной болезнью только 10% лейкоцитов способны при фагоцитозе редуцировать нитроголубон тетразолий. Прогноз ХГБ неблагоприятный. Дети погибают в первые годы жизни.
Характерно образование гранулем и абсцессов в лимфатических узлах, в легких, селезенке, печени, костях. Гранулемы состоят из моноцитарных клеток и большого количества полиморфноядерных лейкоцитов и подвергаются гнойному расплавлению.
В области гранулем обнаруживаются скопления макрофагов, содержащих бурый пигмент и мукополисахариды. В исходе процесса образуются рубцовые изменения. Гистохимическими методами в гистиоцитах-макрофагах обнаруживают мукополисахариды, жирные кислоты. В макрофагах определяется неспецифическая эстераза, в лейкоцитах — оксидаза.
Макрофаги, содержащие мукополисахариды и липиды, встречаются не только в области гнойно-продуктивного воспаления, но и в тимусе, лимфатических узлах, звездчатых эндотелиоцнтах. Во внутренних органах обнаруживаются гранулемы н абсцессы с выраженной капсулой, иногда очень крупные, сливающиеся.
Хронический гнойно-продуктивный процесс сопровождается развитием рубцовой соединительной ткани. В легких эти очаги носят характер так называемой инкапсулированной пневмонии. В мелких костях кистей и стоп остеомиелит имеет характер гранулематозпого процесса без выраженной деструкции и склероза. Кости имеют вид «вздутых».
Отмечаются гепато-, сплепомсгалия, увеличение лимфатических узлов, зависящие не только от наличия гранулем и абсцессов, но и от реакции микрофагальной системы. В селезенке и лимфатических узлах, особенно регионарных, отмечается выраженный миелоз. В тимусе явления резко выраженной атрофии с преждевременным жировым метаморфозом и скоплением макрофагальных элементов, содержащих мукополисахариды.
При электронно-микроскопическом исследовании в цитоплазме макрофагов — большое количество плотных полиморфных гранул, содержащих липиды и белковый компонент, дающий положительную ШИК-реакцию. Высказывается предположение, что это пигмент типа керазина.
Хроническая гранулематозная болезнь
Хроническая гранулематозная болезнь — это редкая форма первичного иммунодефицита, при которой нарушается бактерицидная функция фагоцитов. Является наследственным заболеванием, в основном передается по Х-сцепленному рецессивному типу. Патология проявляется рецидивирующими инфекциями легких, ЖКТ, кожи и других органов. Для диагностики используется проточная цитометрия, генетическое тестирование, микробиологические исследования. Лечение включает антибиотикотерапию, противогрибковые препараты, иммуномодуляторы, в отдельных случаях рекомендована трансплантация костного мозга.
МКБ-10
Общие сведения
Заболевание известно с 1954 г. благодаря ученому C.A. Джейнвею и его коллегам, а генетические причины патологии начали изучаться только в 1980-х гг. Хроническая гранулематозная болезнь (ХГБ) встречается редко, в США ее регистрируют у 1 ребенка на 200-250 тысяч новорожденных. Данные по распространенности в России отсутствуют. Редкость проблемы, недостаточная осведомленность педиатров и терапевтов, сложности в подборе адекватной поддерживающей терапии — все это обуславливает большую актуальность этой хронической наследственной болезни в медицине.
Причины
Болезнь вызвана генетическими мутациями, которые передаются по наследству. Самым частым вариантом является Х-сцепленная мутация в гене gp91-фокс (60-70%). Болеют мужчины, а женщины являются носителями дефектного гена. Оставшиеся случаи приходятся на аутосомно-рецессивный тип наследования, связанный с генными мутациями p22-фокс, p47-фокс, p67-фокс. Этот подтипом заболевания могут страдать больные обоего пола.
Патогенез
В основе хронической гранулематозной болезни лежит дефицит НАДФН-оксидазного комплекса, который образуется при участии цитозольных и мембраносвязывающих белковых единиц. Вследствие мутации генов образование этих протеинов нарушается, в организме пациента не синтезируются ферменты, способные превращать молекулярный кислород в активные формы — супероксидный анион, перекись водорода, синглетный кислород.
Эти окислители в норме вырабатываются гранулоцитами (фагоцитами), составляют основу кислородозависимого этапа фагоцитоза. Он необходим для переваривания отдельных видов бактерий и грибков, продуцирующих фермент каталазу (например, Klebsiella sp, Candida albicans, Aspergillus niger). Остальные звенья клеточного иммунитета не нарушены, поэтому вирусные и паразитарные инфекции встречаются не чаще, чем в среднем в популяции.
Симптомы
Дети с ХГБ рождаются здоровыми, клинические признаки заболевания у них появляются в первые 2 года жизни. В атипичных случаях симптомы Х-сцепленного варианта хронической патологии манифестируют к 5 годам, а при аутосомно-рецессивном наследовании — к 9 годам. Основным признаком болезни являются инфекции, вызванные каталазоположительными Грам+ (Staphylococcus aureus) или Грам- бактериями (E. coli, Serratia liquefaciens, Klebsiella sp., P. aeruginosa, Proteus sp.).
Первичный иммунодефицит в 70-80% случаев манифестирует с рецидивирующих бактериальных инфекций дыхательных путей: тонзиллитов, бронхитов, пневмоний. Инфекционные заболевания отличаются тяжелым течением, умеренным ответом на стандартную антибиотикотерапию, частым переходом в нагноительные процессы. При этом образуются буллы, абсцессы, гангрена легкого.
В дальнейшем у 75-100% пациентов развиваются хронические гнойные лимфадениты, которые проявляются покраснением, припухлостью, болезненностью лимфоузлов. При поражении подмышечных или паховых узлов беспокоит резкая боль при движениях конечностями. В 24-41% случаев формируются гнойные воспаления печени, у 20-30% больных наблюдаются рецидивирующие желудочно-кишечные инфекции, бактериальные и грибковые поражения костей.
Характерным признаком гранулематозной болезни является генерализованный «бецежит», возникающий как осложнение после проведения первой прививки БЦЖ, проявляющийся спустя 1-2 месяца после иммунизации. Патология связана с недостаточностью клеточного иммунитета при введении ослабленных микобактерий Коха. Также после вакцинации есть вероятность начала остеита — формы костного туберкулеза.
Осложнения
Опасное последствие хронической гранулематозной болезни — аспергиллез легких, который провоцирует до 25% случаев смерти среди пациентов. Абсцессы печени чреваты развитием тяжелого гепатолиенального синдрома. Поражение костной ткани грибковым процессом, особенно в области позвоночника и ребер, сопряжено с массивной диссеминацией возбудителя, отличается крайне неблагоприятным прогнозом.
Типичным осложнением иммунодефицита у страдающих гранулематозной болезнью являются неконтролируемые микробные инфекции, которые распространяются по организму с возникновением сепсиса, септицемии, септического шока. При критическом снижении иммунитета, отсутствии своевременной помощи эти заболевания заканчиваются смертью больного. Также при гранулематозной болезни у детей отмечаются задержка роста, отставание в физическом развитии.
Диагностика
При первичной диагностике устанавливаются общие признаки иммунодефицита, выясняется семейный анамнез, степень риска генетической патологии. При физикальном осмотре патогномоничные проявления хронической гранулематозной болезни не определяются. Для постановки диагноза требуется комплексное лабораторно-инструментальное обследование:
- Цитометрия респираторных смывов. Основной способ диагностики, с помощью которого оценивается уровень продукции активных радикалов кислорода. Он подходит для 100% подтверждения хронической генетической патологии, а также для выявления бессимптомных женщин-носительниц гена при Х-сцепленном варианте наследования.
- Генетическое исследование. Рекомендуется по показаниям, чаще в научных целях при подборе экспериментальных методов лечения. Анализ производится методом секвенирования генома, FISH-гибридизации. На ХГБ указывают мутации в генах CYBB, CYBA, NCF1, NCF2 и NCF4.
- Микробиологическая диагностика. Чтобы выявить каталаза-продуцирующие микроорганизмы, проводится бактериоскопия, бакпосев на питательные среды. Для выбора рациональной антибиотикотерапии выполняется тест на антибиотикочувствительность.
- Инструментальная визуализация. Чтобы обнаружить гнойные поражения органов, назначается УЗИ плевральной и брюшной полостей, лимфатических узлов. Также используются рентгенологические исследования (рентгенография, КТ), эндоскопические методы (бронхоскопия, ЭФГДС, колоноскопия).
Лечение хронической гранулематозной болезни
Консервативная терапия
При острых эпизодах микробных инфекций, возникших у пациентов с ХГБ, назначаются стандартные антибиотики из класса макролидов, цефалоспоринов, фторхинолонов. Для терапии грибкового поражения наиболее эффективен амфотерицин В, который принимается длительными курсами. Поддерживающее лечение, которые направлено на снижение риска инфекционных осложнений, включает следующие лекарства:
- Бактерицидные препараты. Для предупреждения бактериальных заболеваний рекомендован длительный прием сульфаниламидов, макролидов.
- Антимикотики. Применяются, чтобы снизить риск аспергиллеза — наиболее опасной грибковой инфекции при хронической гранулематозной болезни.
- Гамма-интерферон. Иммуномодулятор используется, чтобы повысить устойчивость организма к инфекционным агентам, усилить продукцию супероксидных радикалов нейтрофилами.
Экспериментальное лечение
Наиболее перспективным методом терапии больных хронической гранулематозной болезнью считается трансплантация гемопоэтических стволовых клеток, чтобы полностью восстановить нормальную иммунную защиту. Однако пересадка сопряжена с высоким риском осложнений, поэтому проводится ограничено в рамках исследовательских программ. На стадии разработки находятся различные методы генной терапии.
Прогноз и профилактика
Несмотря на применяемые методы лечения, нередко развиваются системные грибковые и бактериальные инфекции с летальным исходом. Прогноз относительно неблагоприятный, наблюдается ухудшение качества и снижение продолжительности жизни больных. Профилактика осложнений предполагает обеспечение постоянной поддерживающей терапии, проведение вакцинации в полном объеме (за исключением БЦЖ), максимальное ограждение пациента от инфекций.
1. Клиническое наблюдение хронической гранулематозной болезни у ребенка 6 лет/ Г.А. Харченко, О.Г. Кимирилова// Детские инфекции. — 2020.
2. Гранулематозное воспаление в манифестации хронической гранулематозной болезни: клинический случай/ Д.В. Юхачева, Д.Е. Першин, Н.Г. Ускова, Г.В. Терещенко, Н.Б. Кузьменко// Школа иммунолога. — 2019.
3. Клинический случай хронической гранулематозной болезни в практике педиатра/ Л.Н. Игишева, М.Н. Ляхова, В.В. Протас, И.В. Силантьева, Т.А. Баканова// Российский вестник перинатологии и педиатрии. — 2017.
4. Диагностика и лечение хронической гранулематозной болезни/ А.С. Прилуцкий, В.А. Дрюченко, Ю.И. Жданюк// Таврический медико-биологический вестник. — 2009.
Гранулематоз Вегенера
Гранулематоз Вегенера – системный некротический васкулит мелких вен и артерий с образованием гранулем в сосудистых стенках и окружающих тканях дыхательных путей, почек и др. органов. Гранулематоз Вегенера характеризуется язвенно-некротическим ринитом, изменениями гортани, придаточных пазух, инфильтрацией легочной ткани с распадом, быстропрогрессирующим гломерулонефритом, полиморфными высыпаниями на коже, полиартралгиями. Диагностика основана на оценке клинико-лабораторных, рентгенологических данных, результатов биопсии. При гранулематозе Вегенера показана гормональная и цитостатическая терапия; прогноз развития заболевания при генерализованной форме неблагоприятный.
Заболеваемость гранулематозом Вегенера одинаково распространена среди мужчин и среди женщин в возрастной группе около 40 лет.
Классификация
С учетом распространенности патологических изменений гранулематоз Вегенера может протекать в локализованной либо генерализованной форме.
В развитии гранулематоза Вегенера выделяются 4 прогрессирующие стадии. Первая стадия гранулематозно-некротического васкулита, или риногенный гранулематоз, протекает с клиникой гнойно-некротического или язвенно-некротического риносинусита, ларингита, назофарингита, деструктивными изменениями костно-хрящевого остова носовой перегородки и глазницы. На следующей стадии (легочной) в патологический процесс вовлекается паренхима легких. При третьей стадии развиваются генерализованные поражения с заинтересованностью нижних дыхательных путей, ЖКТ, сердечно-сосудистой системы, почек. Последняя, терминальная стадия гранулематоза Вегенера характеризуется легочно-сердечной либо почечной недостаточностью, приводящей к гибели пациента в ближайший год от начала ее развития.
Общая симптоматика гранулематоза Вегенера включает лихорадку, ознобы, повышенное потоотделение, слабость, потерю массы тела, миалгии, артралгии, артриты. Ведущим проявлением заболевания, встречающимся у 90% пациентов, служит поражение верхних отделов дыхательных путей. Для клиники гранулематоза Вегенера типично упорное течение ринита, гнойно-геморрагическое отделяемое из носа, изъязвление слизистых оболочек вплоть до перфорации носовой перегородки, седловидная деформация носа. Гранулематозно-некротические изменения развиваются также в полости рта, гортани, трахее, слуховых ходах, придаточных пазухах носа.
У 75% пациентов с гранулематозом Вегенера определяются инфильтративные изменения в легочной ткани, деструктивные полости в легких, кашель с кровохарканьем, свидетельствующий о развитии плеврита плевральный выпот. Вовлечение почек проявляется развитием гломерулонефрита с явлениями гематурии, протеинурии, нарушений выделительной функции. Стремительно прогрессирующее течение гломерулонефрита при гранулематозе Вегенера приводит к острой почечной недостаточности. Изменения со стороны кожи проявляются геморрагической сыпью с последующей некротизацией элементов.
Поражение органов зрения включает развитие эписклерита (воспаления поверхностных тканей склеры), образование орбитальных гранулем, экзофтальм, ишемию зрительного нерва с ухудшением функции зрения вплоть до ее полной утраты. При гранулематозе Вегенера поражаются нервная система, коронарные артерии, миокард.
Локализованная форма гранулематоза Вегенера протекает с преимущественным поражением верхних дыхательных путей – упорным насморком, затруднением носового дыхания, носовыми кровотечениями, образованием кровянистых корочек в носовых ходах, осиплостью голоса. Генерализованная форма характеризуется различными системными проявлениями – лихорадкой, суставно-мышечными болями, геморрагиями, полиморфной сыпью, приступообразным надсадным кашлем с кровянисто-гнойной мокротой, абсцедирующей пневмонией, нарастанием сердечно-легочной и почечной недостаточности.
Диагностика гранулематоза Вегенера
Комплекс диагностических процедур при гранулематоза Вегенера включает консультацию ревматолога, лабораторные анализы, диагностические операции, рентгенологические исследования. Клиническое исследование крови обнаруживает нормохромную анемию, ускорение СОЭ, тромбоцитоз, общий анализ мочи – протеинурию, микрогематурию. При биохимическом анализе крови определяется повышение γ-глобулина, креатинина (при почечном синдроме), мочевины, фибрина, серомукоида, гаптоглобина. Иммунологическими маркерами гранулематоза Вегенера служат антигены класса HLA: DQW7, DR2, B7, B8; наличие антинейтрофильных антител, снижение уровня комплемента.
При рентгенографии легких в их ткани определяются инфильтраты, полости распада, плевральный экссудат. Проводят бронхоскопию с биопсией слизистых верхних дыхательных путей. При исследовании биоптатов выявляются морфологические признаки гранулематозно-некротизирующего васкулита.
Лечение гранулематоза Вегенера
При ограниченной и генерализованной форме гранулематоза Вегенера назначается иммуносупрессивная терапия циклофосфамидом в комбинации с преднизономом. Быстро прогрессирующее течение альвеолита или гломерулонефрита служит показанием к проведению комбинированной пульс-терапии высокими дозами метилпреднизолона и циклофосфамида. При переходе течения гранулематоза Вегенера в стадию ремиссии дозы циклофосфамида и преднизолона постепенно снижают; на длительный (до 2-х лет) срок назначают метотрексат.
Генерализация процесса при гранулематозе Вегенера (кровохарканье, гломерулонефрит, наличие антител к нейтрофильным лейкоцитам) требует проведения экстракорпоральной гемокоррекции - криоафереза, плазмафереза, каскадной фильтрации плазмы, экстракорпоральной фармакотерапии. При лечении рецидивирующего гранулематоза Вегенера эффективно проведение внутривенной иммуноглобулиновой терапии. С целью продления ремиссии может проводиться терапия ритуксимабом. Стенозирующие изменения гортани при гранулематозе Вегенера требуют наложения трахеостомы и реанастомоза.
Осложнения и прогноз
Течение и прогрессирование гранулематоза Вегенера может приводить к деструкции лицевых костей, глухоте вследствие стойкого отита, развитию некротических гранулем в легочной ткани, кровохарканью, трофическим и гангренозным изменениям стопы, почечной недостаточности, вторичным инфекциям на фоне приема иммуносупрессоров. При отсутствии терапии прогноз течения гранулематоза Вегенера неблагоприятный: 93% пациентов погибает в период от 5 месяцев до 2-х лет.
Локальная форма гранулематоза Вегенера протекает более доброкачественно. Проведение иммуносупрессивной терапии способствует улучшению состояния у 90 и стойкой ремиссии у 75% пациентов. Период ремиссии в среднем продолжается около года, после чего у 50% пациентов наступает новое обострение. Прогрессирующее течение ограниченного гранулематоза Вегенера, несмотря на иммуносупрессивную терапию, отмечается у 13% заболевших. Мероприятий по профилактике гранулематоза Вегенера не разработано.
Хроническая гранулематозная болезнь. Причина и клиника
При хронической гранулематозной болезни нейтрофилы и моноциты сохраняют способность поглощать каталазаположительные микроорганизмы, но из-за отсутствия метаболитов кислорода не уничтожают их. Это заболевание встречается редко (4-5:1 000 000) и наследуется рецессивно. Причиной служат мутации генов, кодирующих компоненты НАДФ-оксидазы (одного на Х-хромосоме и трех аутосомных генов).
Генетика и патогенез хронической гранулематозной болезни. Активация НАДФ-оксидазы в нейтрофилах требует сборки в клеточной мембране отдельных субъединиц фермента. Вначале происходит фосфорилирование катионного цитоплазматического белка p47phox (белок «оксидазы фагоцитов» с молекулярной массой 47 кДа). Фосфорилированный p47phox вместе с двумя другими цитоплазматическими компонентами оксидазы — р67phox и низкомолекулярной гуанозинтрифосфатазой (Rac-2) — транслоцируется в клеточную мембрану, где все эти белки взаимодействуют с цитоплазматическими доменами трансмембранного флавоцитохрома b558, образуя активную оксидазу.
Флавоцитохром представляет собой гетеродимер, состоящий из двух пептидов — p22phox и богатого углеводными остатками gp91phox. Согласно современной модели, три трансмембранных домена N-концевой части флавопротеида содержат остатки гистидина, определяющие связывание гема. Пептид р22phoxстабилизирует gp91phox. Роль p40phox в активации оксидазы остается неясной. Пептид gp91phox необходим для транспорта электронов с участием НАДФ-, флавин- и гемсвязывающего доменов. Пептид р22phox не только стабилизирует gp91phox, но и содержит сайты связывания цитоплазматических субъединиц фермента. Цитоплазматические р47phox, р67phox и Rac-2, по-видимому, играют регуляторную роль, активируя цитохром b558.
Примерно 2/3 больных с хронической гранулематозной болезнью — это мужчины, наследующие мутации расположенного на Х-хромосоме гена, который кодирует gp91phox, а 1/3 больных аутосомно-рецессивно наследуют мутацию гена, кодирующего р47phox (хромосома 7). Около 5% больных аутосомно-рецессивно наследуют дефекты генов р67phox (хромосома 1) и р22phox (хромосома 16).
Нормальная фагоцитарная функция нейтрофилов требует активации НАДФ-оксидазы. Электроны переносятся с НАДФ-Н на флавин, затем на гемовую простетическую группу цитохрома b558 и, наконец, на молекулярный кислород, приводя к образованию О2-. При неэффективном функционировании этой системы О2- не образуется.
Нарушения окислительного обмена в нейтрофилах при хронической гранулематозной болезни создают условия для выживания микробов. Среда в вакуолях фагоцитов остается кислой, и бактерии не перевариваются. Окраска макрофагов больных гематоксилин-эозином выявляет золотистый пигмент, отражающий накопление в клетках поглощенного материала, что и лежит в основе диффузного гранулематоза, давшего название этой патологии.
Клинические проявления хронической гранулематозной болезни
Подозревать хроническую гранулематозную болезнь следует у любого больного с повторными или необычными лимфаденитами, печеночными абсцессами, множественным остеомиелитом, частыми инфекциями в семейном анамнезе или инфекциями, вызываемыми каталазаположительными микробами (например, S. aureus).
Клинические признаки и симптомы хронической гранулематозной болезни могут возникать как в грудном, так и в раннем зрелом возрасте. Частота возникновения и тяжесть инфекционных заболеваний крайне непостоянны. Возбудителем обычно является S. aureus, хотя возможно инфицирование любыми другими каталазаположительнымим микроорганизмами. К частым возбудителям инфекций относятся Serratia marcescens, Burkhoderia cepacia, Aspergillus, Candida albicans и Salmonella. Обычно возникают пневмонии, лимфадениты и поражения кожи.
Осложнения хронических инфекций включают анемию, лимфаденопатию, гепатоспленомегалию, хронический гнойный дерматит, рестриктивные нарушения, гингивит, гидронефроз и стеноз привратника. На возможность хронической гранулематозной болезни указывают также парапроктиты и повторные кожные инфекции, в том числе фолликулиты, гранулемы и дискоидная красная волчанка. Гранулемы и воспалительные процессы, если они вызывают стеноз привратника, сужение мочеиспускательного канала или свищи прямой кишки, напоминающие болезнь Крона, требуют безотлагательного подтверждения диагноза.
Читайте также:
- Строение саркомера и сокращение мышцы
- Причины портальной гипертензии. Клиника портальной гипертензии
- Изменение ЭКГ при гипертрофии сердца. Зубцы ЭКГ при гипертрофии
- Тактика при отравлении наркотиками. Поражения желудочно-кишечного тракта токсинами
- Показания и методика временной электрокардиостимуляции (ЭКС)
